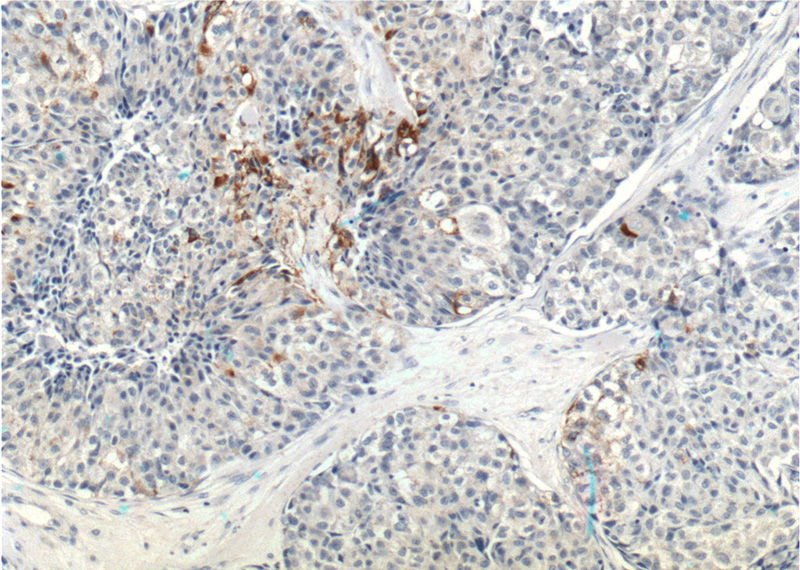
Immunohistochemistry of paraffin-embedded human lung cancer tissue slide using Catalog No:114852(RSPO3 Antibody) at dilution of 1:200 (under 10x lens).

-
Product Name
RSPO3 antibody
- Documents
-
Description
RSPO3 Rabbit Polyclonal antibody. Positive IHC detected in human lung cancer tissue, human placenta tissue. Positive IP detected in human placenta tissue. Positive WB detected in mouse brain tissue, A549 cells, human placenta tissue, Transfected HEK-293 cells. Observed molecular weight by Western-blot: 40 kDa
-
Tested applications
ELISA, WB, IP, IHC
-
Species reactivity
Human,Mouse,Rat; other species not tested.
-
Alternative names
CRISTIN1 antibody; FLJ14440 antibody; hPWTSR antibody; hRspo3 antibody; Protein with TSP type 1 repeat antibody; PWTSR antibody; R spondin 3 antibody; Roof plate specific spondin 3 antibody; RSPO3 antibody; THSD2 antibody
-
Isotype
Rabbit IgG
-
Preparation
This antibody was obtained by immunization of RSPO3 recombinant protein (Accession Number: NM_032784). Purification method: Antigen affinity purified.
-
Clonality
Polyclonal
-
Formulation
PBS with 0.1% sodium azide and 50% glycerol pH 7.3.
-
Storage instructions
Store at -20℃. DO NOT ALIQUOT
-
Applications
Recommended Dilution:
WB: 1:200-1:1000
IP: 1:200-1:1000
IHC: 1:20-1:200
-
Validations

mouse brain tissue were subjected to SDS PAGE followed by western blot with Catalog No:114852(RSPO3 Antibody) at dilution of 1:300

IP Result of anti-RSPO3 (IP:Catalog No:114852, 4ug; Detection:Catalog No:114852 1:300) with human placenta tissue lysate 2800ug.
Immunohistochemistry of paraffin-embedded human lung cancer tissue slide using Catalog No:114852(RSPO3 Antibody) at dilution of 1:200 (under 10x lens).

Immunohistochemistry of paraffin-embedded human lung cancer tissue slide using Catalog No:114852(RSPO3 Antibody) at dilution of 1:200 (under 40x lens).
-
Background
RSPO3, also named as R-spondin-3, is a 272 amino acid protein, which contains 1 TSP type-1 domain and 2 FU (furin-like) repeats. RSPO3 may be a secreted protein and belongs to the R-spondin family. RSPO3 is expressed at higher level in placenta, small intestine, fetal thymus and lymph node. RSPO3 is an activator of the canonical Wnt signaling pathway by acting as a ligand for LGR4-6 receptors. The four R-spondins (RSPO1–4) and three related leucinerich repeat-containing G-protein coupled receptors, LGR4, LGR5, and LGR6 (LGR4–6), constitute a ligand–receptor system that plays critical roles in development, stem cell survival, and oncogenesis. Ectopic expression of RSPO2/3in mouse mammary epithelial cells led to an increase in invasiveness in vitro and in tumor formation and metastasis in vivo.
-
References
- Carmon KS, Gong X, Yi J, Thomas A, Liu Q. RSPO-LGR4 functions via IQGAP1 to potentiate Wnt signaling. Proceedings of the National Academy of Sciences of the United States of America. 111(13):E1221-9. 2014.
Related Products / Services
Please note: All products are "FOR RESEARCH USE ONLY AND ARE NOT INTENDED FOR DIAGNOSTIC OR THERAPEUTIC USE"
